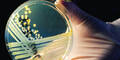
Forscher identifizieren Bakterium

Die Behörden seien gescheitert - Russland will Gespräche mit Deutschland.
Russland hat in der EHEC-Krise schwere Vorwürfe gegen Deutschland erhoben. Die deutschen Behörden seien gescheitert beim Versuch, "die Quelle des hochansteckenden E.coli in der menschlichen Nahrungskette nachzuweisen". Das teilte die staatliche Veterinäraufsicht am Freitag nach Angaben der Agentur Interfax in Moskau mit. Wegen des gefährlichen Darmkeims EHEC hatte Russland Anfang Juni ein Importverbot für Gemüse aus allen 27 EU-Staaten beschlossen.
Die Veterinäraufsicht zeigte sich "ernsthaft besorgt" und will deutsche Tierärzte zu Gesprächen über die Gründe für die Seuche nach Moskau bitten. Zudem wolle Russland erfahren, inwiefern die Möglichkeit eines Dioxin-Befalls von Tierfutter und -produkten ausgeschlossen werden könne. Ein möglicher Termin für die Gespräche seien der 27. und 28. Juni in Moskau, hieß es.